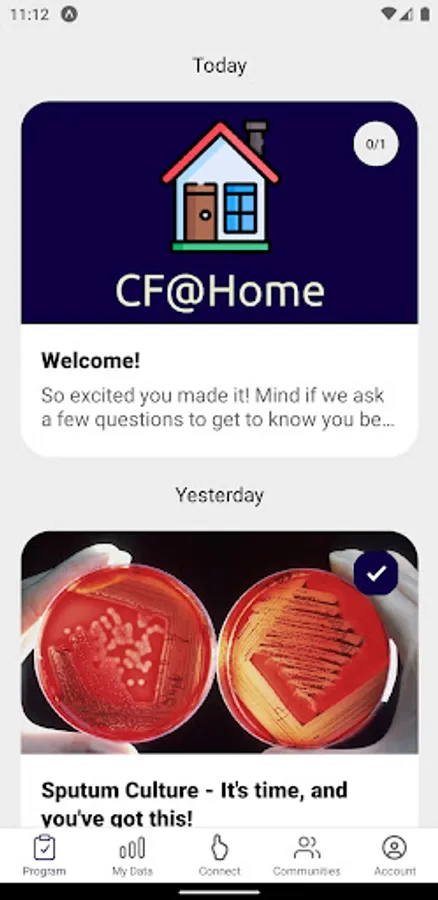

About CF@Home
The best CF care starts at home with CF@Home.
CF@Home was designed to improve routine health maintenance and disease monitoring by empowering users to take charge of their own health monitoring. This app provides guidance, education, and reminders for when self-monitoring and screening tests are due.
Download CF@Home today, and start maintaining your health with fewer in-person clinic visits.
This app does not provide medical advice, diagnosis or treatment. If you have questions about a medical condition, always seek the advice of your physician or other qualified health provider. Never disregard or delay seeking professional medical advice because of something you read in this app.
CF@Home was designed to improve routine health maintenance and disease monitoring by empowering users to take charge of their own health monitoring. This app provides guidance, education, and reminders for when self-monitoring and screening tests are due.
Download CF@Home today, and start maintaining your health with fewer in-person clinic visits.
This app does not provide medical advice, diagnosis or treatment. If you have questions about a medical condition, always seek the advice of your physician or other qualified health provider. Never disregard or delay seeking professional medical advice because of something you read in this app.
CF@Home Screenshots
Tap to Rate: